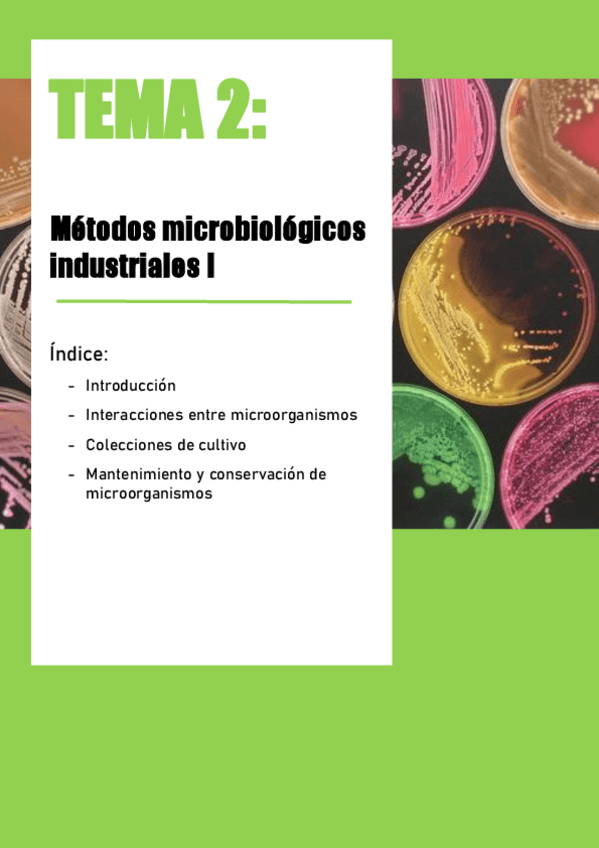

Microbiología Industrial
He publicado nuevos apuntes de 3º Microbiología Industrial: MIND-Microorganismos-importantes.pdf
apuntes
-
Apuntes mind
He publicado nuevos apuntes de 3º Microbiología Industrial: Apuntes mind
apuntes
-
Apuntes MIND
He publicado nuevos apuntes de 3º Microbiología Industrial: Apuntes MIND
apuntes
-
Apuntes MIND
He publicado nuevos apuntes de 3º Microbiología Industrial: Apuntes MIND
He publicado nuevos apuntes de 3º Microbiología Industrial: resumen-pa-perdios.pdf
He publicado nuevos test de 3º Microbiología Industrial: Cuestionario-Test-1-MIND.pdf
He publicado nuevos apuntes de 3º Microbiología Industrial: Resumen-Completo-Examen.pdf
He publicado nuevos practicas de 3º Microbiología Industrial: Memoria-MIND-Extractos-Naturales-gulag-free.pdf
He publicado nuevos practicas de 3º Microbiología Industrial: Memoria-MIN-Metabolito-Secundario-gulag-free.pdf
He publicado nuevos practicas de 3º Microbiología Industrial: Memoria-MIND-Identificacion-y-Yogur-gulag-free.pdf
He publicado nuevos examenes de 3º Microbiología Industrial: MIND-Examen-Junio-2024.pdf
muchas repetidas pero estan todas las preguntas porque siempre falta alguna en los documentos que ya hay
He publicado nuevos examenes de 3º Microbiología Industrial: Cuestionario-Opcion-Multiple-Completo-MIND.pdf
He publicado nuevos test de 3º Microbiología Industrial: Cuestionario-Bloque-I-MIND.pdf
apuntes
-
TEMARIO MIND
He publicado nuevos apuntes de 3º Microbiología Industrial: TEMARIO MIND
He publicado nuevos practicas de 3º Microbiología Industrial: PRACTICAS-3-Y-4.pdf
He publicado nuevos practicas de 3º Microbiología Industrial: PRACTICA-2.pdf
He publicado nuevos apuntes de 3º Microbiología Industrial: MIND.-memoria.pdf
He publicado nuevos apuntes de 3º Microbiología Industrial: MIND.-cuestiones.pdf
He publicado nuevos examenes de 3º Microbiología Industrial: Recopilatorio-test-MIND-22-23.pdf
He publicado nuevos apuntes de 3º Microbiología Industrial: MEMORIA-MICROBIOLOGIA-INDUSTRIAL NOTA 10.pdf
apuntes
-
PRÁCTICAS MIND
He publicado nuevos apuntes de 3º Microbiología Industrial: PRÁCTICAS MIND
He publicado nuevos apuntes de 3º Microbiología Industrial: APUNTES-PARA-EXAMEN.pdf
He publicado nuevos apuntes de 3º Microbiología Industrial: Microbiologia-Industrial-Apuntes.pdf
He publicado nuevos apuntes de 3º Microbiología Industrial: TESTMIND2022.pdf
apuntes
-
Apuntes 2022
He publicado nuevos apuntes de 3º Microbiología Industrial: Apuntes 2022
He publicado nuevos apuntes de 3º Microbiología Industrial: mis-apuntes-mind.pdf
He publicado nuevos apuntes de 3º Microbiología Industrial: Microorg-importantes-en-la-Industria-Examen.pdf
He publicado nuevos test de 3º Microbiología Industrial: Recopilacion-Test-MIND-Completo.pdf
He publicado nuevos apuntes de 3º Microbiología Industrial: PREGUNTAS-TEST.pdf
apuntes
-
ESQUEMAS TEMAS 1-6
He publicado nuevos apuntes de 3º Microbiología Industrial: ESQUEMAS TEMAS 1-6
He publicado nuevos apuntes de 3º Microbiología Industrial: TRABAJO-MIND-Biodiesel-a-partir-de-Microalgas.pdf
apuntes
-
Memoria prácticas de laboratorio
He publicado nuevos apuntes de 3º Microbiología Industrial: Memoria prácticas de laboratorio
He publicado nuevos test de 3º Microbiología Industrial: Test-MIND-Temas-8-10.pdf
He publicado nuevos test de 3º Microbiología Industrial: Revision-de-Test-MIND-Temas-5-7.pdf
He publicado nuevos test de 3º Microbiología Industrial: Test-MIND-Temas-1-4.pdf
apuntes
-
Resúmenes por temas completos
He publicado nuevos apuntes de 3º Microbiología Industrial: Resúmenes por temas completos
He publicado nuevos examenes de 3º Microbiología Industrial: Preguntas-test-campus.pdf
He publicado nuevos apuntes de 3º Microbiología Industrial: T7MINDcompleto.pdf
He publicado nuevos apuntes de 3º Microbiología Industrial: Diagrama-de-bloques67.pdf
He publicado nuevos apuntes de 3º Microbiología Industrial: T7MIND-lacteos.pdf
He publicado nuevos apuntes de 3º Microbiología Industrial: Apuntes-MIND-asignatura-completa.pdf
He publicado nuevos examenes de 3º Microbiología Industrial: EXAMEN-MIND-JUNIO-19.pdf
He publicado nuevos apuntes de 3º Microbiología Industrial: Microorganismos mencionados en el temario.pdf
He publicado nuevos apuntes de 3º Microbiología Industrial: Tema 4. Resumen.pdf
He publicado nuevos apuntes de 3º Microbiología Industrial: Tema 9. Resumen.pdf
apuntes
-
Resumen Tema 10 - Producción de Bioetanol
He publicado nuevos apuntes de 3º Microbiología Industrial: Resumen Tema 10 - Producción de Bioetanol